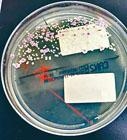

Tag: 港聞
不滿警進入搜捕 黃埔居民圍保安十句鐘
(星島日報報道)有示威者昨凌晨在港鐵黃埔站外堵路,防暴警到場拘捕三人,並進入黃埔花園搜捕其他示威者,其間有住客發現,不滿保安員容許警員進入屋苑範圍執勤,群起包圍有關保安員,更威嚇若無滿意解釋,來年農曆新年將不給予保安員利是。
家門離奇爆炸燒屋 少女裹被爬窗墮斃
(星島日報報道)牛池灣彩雲邨昨午發生離奇奪命火警,十樓一個單位發生爆炸及湧出火球,一名十九歲女住客在起火單位窗邊,裹着棉被呼叫,其間疑爬出避火時失足墮樓身亡,消防員迅即將火撲熄後,在單位廁所發現死者的母親及外婆,兩人疑吸入濃煙,送院搶救俱命危,警方及消防處正深入調查起火原因。
烏龍七惡煞砸錯食肆再斬人
(星島日報報道)七名「烏龍」黑衣煞星疑「摸錯店鋪」,昨凌晨分持利刀鐵通,搗毀深水埗福華街一家串燒店魚缸才知去錯地點,之後再到毗鄰新開張店鋪,斬傷東主及一名職員逃去,警方不排除血案與黑幫勒收「陀地費」不遂有關,無辜殃及串燒店東主一臉無奈。
新田購物城塌閘壓斃保安
(星島日報報道)六十二歲姓陳女保安員,前午五時在落馬洲新田購物城當值期間,疑拉開一道金屬車閘時,重約一百多公斤車閘突然塌下,將其上半身壓着,傷重昏迷,消防員救出送院,證實不治,警方列工業意外處理,稍後剖屍檢驗。勞工處發言人稱,已就事件跟進調查。
羅致光考察日本樂齡科技
(星島日報報道)本港人均壽命長,同時面對人口老化問題。勞福局局長羅致光昨發表網誌,他近日到日本東京考察當地對人口高齡化的應對策略,參觀樂齡科技的最新發展,將有社福機構獲馬會資助,推行樂齡器材租賃服務先導計畫,細節有待公布;另外亦探討借鏡當地為體弱長者製造各式軟餐的服務,提升長者生活質素。
河套區擬設12.8公頃生態區
(星島日報報道)位於港深之間,將發展為創科園的河套地區現正進行土地平整工程。發展局局長黃偉綸指,將在河套區東南面,鄰近舊深圳河河曲的位置設立一個佔地十二點八公頃的生態區,區內將有四個蘆葦沼澤區及一個淡水沼澤區,希望能吸引雀鳥、歐亞水獺等動物棲息和繁殖,與舊深圳河河曲及魚塘融合相連,形成連貫濕地,充分發揮生態區的功能和價值。政府指目前有關工程進展理想,料二○二一年或以前可按時提供首幅用地。
耳念珠菌耐藥性高 公院加強篩查半年
(星島日報報道)全球首次在○九年於日本發現耳念珠菌,其後迅速傳播至二十多個國家,其抗藥性十分高,外國患者死亡率約兩至六成。本港瑪嘉烈醫院及北大嶼山醫院近月爆發耳念珠菌,十六人均屬帶菌者並無感染。醫管局總感染控制主任賴偉文表示,近數星期已再無錄得新個案,認為爆發期已完結,但不能排除再有爆發風險,故加強篩查計畫至少半年,為入住深切治療部等高危病房及過去一年曾經在海外入院的病人作耳念珠菌化驗。
東涌東新路將落成 九巴增往來市區線
位於東涌東的新發展區於近年逐漸成型,坐擁東環及昇薈兩大私人屋苑,連同鄰近的迎東邨,組成提供逾七千伙的住宅群,惟區內私人屋苑沒有提供穿梭車,居民出入只能依賴巴士,一直被交通問題所困擾。東涌居民關注組主席劉永賢表示,東涌新發展區一帶人口漸增,惟道路設施及巴士線明顯未跟上,因此區內不少居民組織一直向政府及區議員表達訴求,包括申請於鄰近填海區的迎東邨興建巴士總站,應付大增的人流。
「連登仔」組自由系 11月首戰區選
(星島日報報道)反修例運動令網上討論區「連登」爆紅,網民由昔日的「鍵盤戰士」,變為落場實戰,一班「連登仔」更組成參政平台「自由系」,進軍十一月舉行的區選。現職公關公司總裁的劉卓裕是「自由系」其中一員,目前落戶荃灣愉景區參與地區工作,首次參政更即刻「打大佬」,擬挑戰實政圓桌雙料議員田北辰,他笑言挑戰難度極高,但自己會比對方花更多時間關注區政。
陳茂波籲市民與暴力割席
(星島日報報道)反修例示威行動不斷,財政司司長陳茂波表示,近月激進的抗爭及不合作運動,已令本已疲弱的香港經濟受到更沉重的打擊,直言「正進入一個非常困難的經濟環境」。陳茂波呼籲市民與暴力割席,「任何對暴力的讓步,只會助長更多的暴力」,強調對政府有不滿,絕不等如要包容、縱容暴力行為。
環時》總編抨海港城「態度曖昧」
網民早前計畫於尖沙嘴海港城發起不合作運動,因海港城張貼告示,「我們盡力確保場內顧客安全。除非有罪案發生,警察請勿進入。」及後示威者亦取消行動。《環球時報》總編輯胡錫進前晚批評,指海港城是暴徒兩次把國旗降下、愛國愛港人士又兩次將國旗升起的地方,質疑國旗受侮辱時其保安力量,認為海港城並沒有表現出與惡勢力作鬥爭的任何努力。
工商聯指港經濟陷外憂內患
(星島日報報道)反修例示威行動持續,影響已開始蔓延至經濟、民生層面。全國工商聯向香港市民發表公開信,指持續的亂局已經令香港經濟陷入外憂內患的境地,希望市民同心「止暴制亂」,讓社會可以重新出發,聯署人包括全國工商聯副主席、恒基地產主席兼董事總經理李家傑。
譚耀宗:逼駐軍出動 「玉石俱焚」心態累事
(星島日報報道)反修例爭議愈演愈烈,港澳辦主任張曉明日前指若局勢進一步惡化,出現特區政府不能控制的動亂,中央絕不會坐視不管,強調中央有足夠多的辦法迅速平息動亂。全國人大常委譚耀宗(見圖)表示,現時有部分人故意挑釁,抱有「逼中央出手」出動駐港解放軍以同歸於盡、玉石俱焚,形容這種心態很「累事」。
謝偉銓倡調查擴至元朗等事件
(星島日報報道)反修例引發連串警民衝突,警方處理示威手法備受質疑,監警會副主席謝偉銓(見圖)昨表示,至今已收到逾二萬份涉及過去兩個多月衝突的片段或資料,當中有一千二百份會再作進一步詳細分析,警方最快未來數天會提供資料。他又說,原則上應將調查擴大至元朗站等襲擊事件,但不排除會分開交報告。政務司司長張建宗亦表示,監警會專責組已就近期發生的衝突事件,開始收集資料,警方亦會配合。
福建幫囤重兵 示威者卻步
北角英皇道一帶,昨只有少數商鋪落閘,其他商鋪大多營業,包括一家酒樓,中午過後有逾千名福建同鄉聚餐,他們身穿同一款紅衣或衣袖貼上國旗貼紙,又在酒樓門外及對開交通路牌懸掛國旗,警員不時巡查,其間前立法會議員劉小麗乘車經過,被中年漢包圍拍打車身,司機下車理論,終由警員勸喻離開,氣氛外弛內張,大有山雨欲來之勢。
「接機」和平抗議 合唱《孤星淚》
(星島日報報道)反對修訂《逃犯條例》人士一連三日在機場一號客運大樓抵港大堂舉行「萬人接機」行動,重申五大訴求,並向旅客解釋本港「反修列」風波,昨日第二天集會仍有逾二千名市民響應,行動大致和平進行,有集會人士在晚上發起靜默示威,抗議政府打壓市民。因應集會人潮,機管局加強管制,並加派職員和保安協助旅客。
八月頭七天內地團 較上月少四成
(星島日報報道)本港近月示威持續,致旅遊業吹淡風。業界透露,本月首七日的內地訪港團數量,較七月同期下跌達四成。由於不少海外人士首次踏足本港,均會選擇跟隨旅行團出發,若訪港旅行團人數持續減少,則可預料日後「翻頭客」數量亦會大減,業界認為不僅對旅遊業影響深遠,連帶打擊飲食、零售及運輸業。
國泰應民航局要求交機組名單
對於民航局發出重大航空安全風險警示及三項要求,國泰昨日迅即回應並採取相關行動。國泰昨回應本報查詢,指收到乘客及公眾就一名被控暴動罪的國泰機師查詢,公司已按機師飛行職務的標準程序處理,有關機師自七月三十日起已沒有被安排飛行職務,並於上月十五日起沒有執行任何飛行任務。另有兩名機場員工因行為不當被解僱,據悉被解僱的為涉及泄露警員資料的地勤員工。
「全民撐警日」 多個團體送心意卡
(星島日報報道)反修例示威行動不斷,警民衝突升級。「守護香港大聯盟」昨發起「全民撐警日」,多個團體和市民響應,前往多家警署向警隊致送心意卡、慰問信等。全國政協委員、大聯盟召集人黃英豪稱,警隊處理今次反修例的示威遊行相當文明,又認為警察工時長且常受到挑釁和侮辱,十分辛苦。團體並擬推動每年八月十日定為「香港警察日」。
「守護孩子未來」集會 800人出席
另外,有市民昨發起「銀髮族」遞信活動,往特首辦等地點遞交請願信,要求警察遵守其畢業誓詞,以不徇私、不對他人懷惡意等態度執行職務,及要求政府正式撤回《逃犯條例》修訂草案。有長者不滿政府處理修例及遊行示威衝突的手法,更多人要求政府盡快設立獨立調查委員會,徹查近期警民衝突事件。